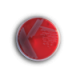
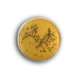

Готовые среды в чашках Петри — это стерильные, стандартизированные и полностью подготовленные к использованию диагностические среды, предназначенные для работы в лабораториях клинической микробиологии. Они обеспечивают надёжное выделение, культивирование и первичную идентификацию микроорганизмов из клинического материала различного происхождения.
Использование готовых чашек позволяет исключить этап самостоятельного приготовления среды, минимизировать человеческий фактор и значительно повысить воспроизводимость результатов.